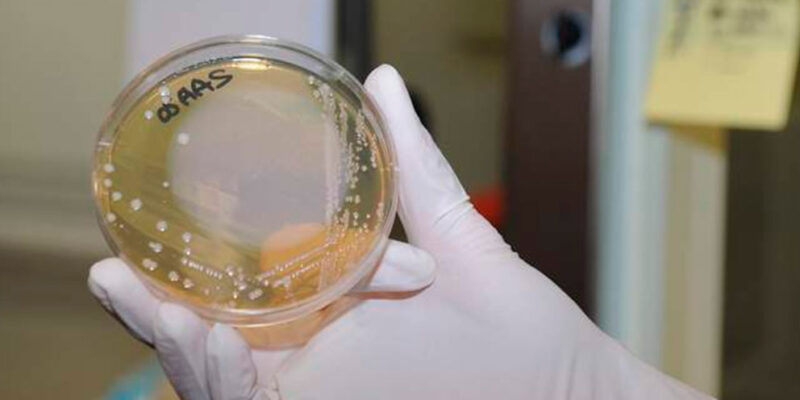

La semana pasada, Japón se vio sacudido por un aumento sin precedentes en los casos de síndrome de shock tóxico estreptocócico (STSS), una infección bacteriana conocida como la «enfermedad carnívora» debido a su capacidad para provocar necrosis de los tejidos conectivos en su forma más grave. Este alarmante incremento ha generado una alerta en todo el país y ha puesto en alerta a las autoridades sanitarias.
Según un informe del Instituto Nacional de Enfermedades Infecciosas de Japón, el número de pacientes diagnosticados con STSS en 2023 alcanzó la cifra récord de 941, superando significativamente el récord anterior establecido en 2019, que era de 894 casos. Esta situación ha llevado a las autoridades a tomar medidas urgentes para comprender y contener la propagación de esta infección potencialmente mortal.
El STSS es causado principalmente por bacterias del grupo A de estreptococos, que se transmiten a través de pequeñas gotas de saliva. Se estima que aproximadamente el 30% de los casos de STSS resultan en muerte debido a la rápida progresión de los síntomas. Esta enfermedad se ha vuelto especialmente preocupante entre adultos mayores de 30 años, y se han registrado varias muertes en cuestión de horas debido a fallos orgánicos múltiples.
El aumento repentino de los casos ha desconcertado a los expertos, quienes aún no han identificado la causa exacta de esta explosión de infecciones. Se ha sugerido que el repunte de enfermedades respiratorias tras la eliminación de las restricciones por la pandemia en 2023 podría estar relacionado con este fenómeno, aunque se requiere una investigación más profunda para confirmarlo.
El Ministerio de Salud japonés ha emitido un llamado a los gobiernos locales para analizar muestras tomadas de pacientes y determinar las cepas circulantes en el país. Asimismo, se han instado a la población a tomar medidas preventivas básicas, como lavarse las manos regularmente y tratar adecuadamente las heridas para reducir el riesgo de infección.
Los síntomas del STSS pueden variar desde dolor de garganta, fiebre y fatiga hasta complicaciones graves como insuficiencia renal, dificultad respiratoria aguda y coagulación intravascular diseminada. Esta enfermedad puede progresar rápidamente y llevar a la muerte en un corto período de tiempo, lo que ha generado una preocupación generalizada en todo el país.
El aumento de casos de STSS se suma a la creciente incidencia de otras enfermedades respiratorias y virales desde el levantamiento de las restricciones por la pandemia, lo que ha generado un ambiente de alerta en el sistema de salud japonés. Las autoridades están trabajando arduamente para contener la propagación de estas infecciones y proteger la salud de la población.
A pesar de que la noticia inicialmente tuvo un impacto significativo en Japón, su repercusión se extendió a nivel internacional cuando medios como The Guardian resaltaron el creciente desafío que enfrenta el país frente a esta infección bacteriana. Esta situación refleja la importancia de la vigilancia epidemiológica y la respuesta rápida ante amenazas emergentes para la salud pública.
Comments